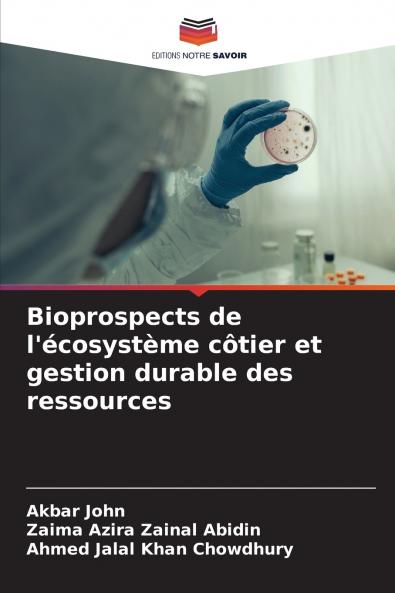
Bioprospects de l'écosystème côtier et gestion durable des ressources

Paperback
₹3738
₹5162
27.59% OFF
(All inclusive*)
Delivery Options
Please enter pincode to check delivery time.
*COD & Shipping Charges may apply on certain items.
Review final details at checkout.
Looking to place a bulk order? SUBMIT DETAILS
Delivery Options
Please enter pincode to check delivery time.
*COD & Shipping Charges may apply on certain items.
Review final details at checkout.
About The Book
Description
Author(s)
Ce livre est une collection complète de données issues de la recherche sur les écosystèmes côtiers de Malaisie (en particulier de la côte est de la Malaisie péninsulaire). Le livre se compose de neuf chapitres qui traitent des questions liées (mais pas seulement) au potentiel de bioprospection comme le dépistage des actinomycètes de l'écosystème côtier la bioprospection microbienne en utilisant l'approche omique l'importance de l'aquaculture multi-trophique intégrée la diversité biotique et l'érosion du littoral dans l'écosystème côtier. Nous sommes optimistes et pensons que les connaissances approfondies et les idées scientifiques partagées dans cet ouvrage contribueront à la réalisation des objectifs de développement durable dans leur ensemble et en particulier des objectifs 13 14 et 15.
Details
ISBN 13
9786203507058
Publication Date
-18-03-2021
Pages
-128
Weight
-184 grams
Dimensions
-152x229x7.64 mm